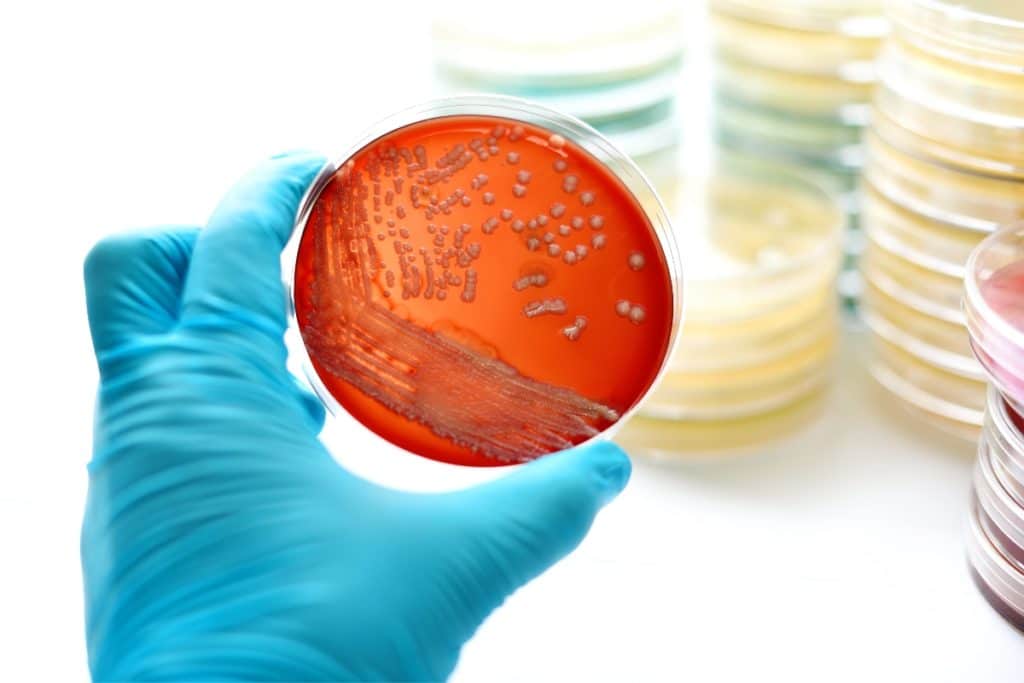
Cientistas descobrem bactéria amazônica com potencial para combater doenças como herpes e câncer de mama

Composto estudado por cientistas do Instituto Tecnológico Vale (ITV), da Universidade Federal do Sul e Sudeste do Pará (Unifesspa) e de instituições parceiras demonstrou propriedades viricidas, bactericidas e capaz de eliminar células cancerosas

Um estudo realizado por cientistas do Instituto Tecnológico Vale (ITV-DS), da Universidade Federal do Sul e Sudeste do Pará (Unifesspa) e de instituições parceiras descreve de forma animadora o potencial terapêutico de um composto químico produzido por uma nova bactéria encontrada no solo amazônico na região de Paragominas, leste do Pará. O composto químico demonstrou propriedades viricidas, bactericidas e foi capaz de eliminar células cancerosas sem danificar células saudáveis, segundo os descobridores.
A pesquisa estudou o potencial farmacêutico de uma cepa de bactéria da espécie Pseudomonas aeruginosa. A bactéria produz um surfactante de origem microbiana ou biossurfactantes chamado de ramnolipídeo. Esse composto demonstrou resultados promissores contra microrganismos patogênicos de interesse médico e veterinário. O estudo avaliou também a toxicidade do composto em relação a três tipos de vírus (herpes simples, coronavírus murino e vírus sincicial respiratório). Uma solução do composto, com uma concentração de 250 μg/mL, inibiu 97% da atividade viral nos três tipos de vírus citados. Observaram-se resultados semelhantes com uma solução de 50 μg/mL, por 15, 30 e 60 minutos. Então, sugeriu-se que a eficácia viricida está relacionada ao tempo de exposição do vírus ao biossurfactante.
Ramnolipídeo (biossurfactante)
Um outro teste mostrou que o ramnolipídeo (biossurfactante), na concentração de 12,5 µg/mL, apresentou potencial seletividade na redução da proliferação de células tumorais de mama. Isto aconteceu após um minuto de exposição em laboratório.
Para José Pires Bitencourt, do ITV e um dos autores do artigo, o composto é uma substância que auxilia a bactéria a captar algum nutriente que seja interessante para o seu crescimento. Além disto, também auxilia na comunicação entre bactérias da mesma espécie. Segundo ele, durante o estudo, todas as concentrações do composto diminuíram a viabilidade das células cancerígenas para menos de 50% em 72 horas, demonstrando um potencial antitumoral comparável aos níveis alcançados pela quimioterapia padrão.
Bitencourt explica que as condições ambientais do solo amazônico são propícias para compostos de interesse farmacêutico, como o estudado pela pesquisa. “Diferentes subespécies de bactérias encontradas em várias condições de solo produzem biossurfactantes, influenciadas por fatores como clima, evolução do solo, regime hídrico, interação com outros organismos e impacto humano”.
Para Sidnei Cerqueira dos Santos, professor da Universidade Federal do Sul e Sudeste do Pará (Unifesspa) e um dos autores do artigo, o ramanolipídeo também “pode ser usado como estratégia de sobrevivência dessas bactérias em ambientes desfavoráveis, para reduzir ou inibir a toxicidade celular, como por exemplo solo contaminado por metais”. O composto apresenta grande potencial para o desenvolvimento de novas formulações para o controle de microrganismos, vírus e tratamento do câncer de mama. Com informações do Media Relations Office – Vale.
Fonte: labnetwork
ÚLTIMAS NOTÍCIAS: ÁGUA POSITIVA: UMA TENDÊNCIA CRESCENTE DE SUSTENTABILIDADE HÍDRICA EMPRESARIAL
ÚLTIMAS NOTÍCIAS: ALAGOAS TERÁ USINA DE COMBUSTÍVEL LIMPO E RENOVÁVEL